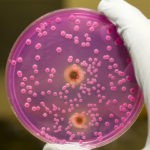
Острый бронхит диагностируют на основании лабораторного исследования посева мокроты

Мокрота при бронхите
Бронхит – заболевание, развивающееся на фоне воспалительных процессов слизистой оболочки дыхательных путей. Причин воспаления бронхов множество: инфекции, аллергены, химические реагенты. Основным симптомом бронхита является изнуряющий кашель: сухой или влажный. При бронхите в дыхательных путях вырабатывается большое количество слизи и появляется мокрота. Она состоит из секрета бронхов, отмерших клеток, пыли и представляет собой удобную среду для размножения болезнетворной микрофлоры. Посредством кашля организм пытается избавиться от вредных веществ.

Болезнь может иметь острую форму, при которой повреждены лишь верхние слои эпителия бронхов, и хроническую, при которых патология захватывает более глубокие слои. Если бронхит не лечить, то на его фоне у пациента разовьются тяжелые формы одышки и бронхиальная астма.
Мокрота при бронхите может иметь различный цвет, запах, консистенцию.
Классификация
Мокроту, выделяющуюся при бронхите, можно классифицировать по следующим признакам:
- консистенции;
- цвету;
- прозрачности;
- запаху;
- вязкости.
По консистенции мокрота при бронхите может быть слизистой, слизисто-гнойной или гнойной. По цвету – белой, желтой, зеленой, коричневой (у курильщиков), розовой, красной, черной (у шахтеров). По прозрачности выделения бывают прозрачными или замутненными.

Изучив характер мокроты при бронхите, опытный врач может поставить диагноз, определить причину заболевания и его стадию.
Мокрота при остром бронхите
Характер мокроты при остром бронхите:
- слизистая, прозрачная или белого цвета, часто с вкраплениями гноя (желтоватого или зеленоватого оттенка);
- однослойная;
- вязкая, однородная;
- выраженные запахи гниения отсутствуют;
- содержит небольшое количество кровяных прожилок.
Мокрота при хроническом бронхите
Если заболевание находится на начальном этапе хронической стадии в фазе ремиссии, то количество выделяемой слизи скудно. В зависимости от причины возникновения болезни слизь может быть как бесцветной, так и иметь оттенки от желтоватого до черного.

При обострении хронического бронхита у больного отмечается кашель, а количество слизи резко увеличивается. При этом выделения густеют, мутнеют, становятся слизисто-гнойными или гнойными, приобретают желтоватый или зеленоватый оттенок и неприятный гнилостный запах.
Мокрота при хроническом обструктивном бронхите
Хронический обструктивный бронхит – это более тяжелая стадия хронического бронхита, при которой страдают не только бронхи, но и легкие.
При обструктивном бронхите мокрота, имеющая те же характеристики, что и при обострениях начальной стадии заболевания, способствует резкому ухудшению состояния человека.
Диагностика
Острый бронхит диагностируют на основании клинических проявлений и данных обязательных инструментальных и лабораторных исследований, к которым относятся:
- рентгенография легких;
- бронхоскопия;
- анализы крови и мочи;
- посев мокроты.
К диагностике заболевания необходимо подходить с особой тщательностью, т. к. бронхит может быть как самостоятельным заболеванием, так и проявлением многих инфекционных патологий, таких как корь, коклюш и др.
Анализ
При бронхите состав мокроты меняется, в ней появляются:
- болезнетворные микроорганизмы;
- бактерии;
- клетки крови, эпителия, иммунной системы;
- частицы распада клеток и тканей.
Таким образом, мокрота является важным биологическим материалом, анализируя который, врач получает исчерпывающую информацию о возбудителях и характере протекания болезни и может подобрать оптимальные средства борьбы с ней.
В качестве дополнительного источника информации специалисты анализируют и внешние признаки слизи: запах и цвет.
Запах
При остром бронхите и на начальной стадии хронического заболевания в фазе ремиссии мокрота запаха не имеет. При обострении хронического и обструктивного бронхита мокрота приобретает неприятный запах различной интенсивности.

Цвет
Небольшое количество белой слизи считается нормой.
Желтый оттенок мокроте придает избыточное количество лейкоцитов, характеризующее хронический бронхит аллергического и инфекционного происхождения.
Зеленый цвет указывает на присутствие застарелой инфекции. В такой слизи могут присутствовать гнойные выделения.
Коричневая мокрота говорит о распаде эритроцитов и указывает на то, что в прошлом в дыхательных путях были кровоизлияния.
Каким бы ни был цвет мокроты при бронхите, сдавать ее на анализ лучше всего утром натощак, т. к. некоторые продукты могут изменять оттенок слизи.
Мокрота с кровью
При бронхите в результате надрывного кашля часто происходит повреждение сосудов дыхательных путей, на это указывает мокрота с кровью. Если прожилки крови присутствуют в небольшом количестве, то волноваться не стоит. Большое количество кровяных выделений говорит о более тяжелых заболеваниях: бронхиальной астме, пневмонии, туберкулезе. Эти патологии часто сопровождаются сильным кровохарканьем, а в последнем случае возможны и горловые кровотечения.

Как вывести мокроту при бронхите?
Бороться с мокротой при бронхите можно несколькими способами:
- Прогревать орган горчичниками или компрессами. Прогревания разжижают мокроту и облегчают ее выведение.
- Пить больше воды. Употребление жидкости также способствует разжижению мокроты. А щелочная минеральная вода без газа помогает смягчить кашель.
- Ингаляции. При необходимости их можно проводить каждые 2 часа.
- При помощи средств народной медицины.

Ингаляции
Паровые ингаляции – простой и действенный способ устранения мокроты. Такая домашняя терапия помогает ликвидировать и симптомы заболевания, и причину его развития. Действие пара активизирует кровообращение в зоне дыхательных путей, чем усиливает отхождение мокроты. Травы и другие компоненты, входящие в состав ингаляции, оказывают отхаркивающее и дезинфицирующее действия. Если мокрота плохо отходит, то лучше всего помогают ингаляции:
- с солью и содой: на 1 стакан воды 2,5 г соды и 5 г соли;
- с Валидолом: 1 таблетка на 1 л горячей воды;
- с отварами листьев ромашки, эвкалипта и сосновых почек.

Народные средства
Избавиться от трудноотделяемой мокроты помогут народные рецепты на основе растений и продуктов, обладающих отхаркивающим действием. Наиболее эффективными натуральными средствами, помогающими откашливаться, являются:
- настойка на основе березовых листьев, душицы, крапивы и багульника;
- отвар ромашки, мать-и-мачехи и душицы;
- смесь сока редьки с медом;
- вареный овес с молоком;
- состав на основе сока алоэ, меда и сливочного масла;
- теплое молоко с медом и коньяком;
- лук и чеснок – мощные антибактериальные, антимикробные и противовоспалительные средства.

Постуральный дренаж
Постуральный дренаж – это комплекс лечебно-массажных мероприятий, призванных очистить дыхательные пути от чрезмерного количества мокроты.
При простых формах пневмонии и бронхита дренаж не проводят. Этот метод применяют только в наиболее тяжелых клинических ситуациях:
- при обострении муковисцидоза;
- при воспалении обоих легких на фоне инфекционного поражения бронхиального дерева;
- при метастазирующем раке легочных тканей;
- при спазмах в бронхах астматического характера.

Методика постурального массажа включает в себя комплекс манипуляций в виде постукиваний, поглаживаний и хлопков. За счет силы тяжести, учитываемой в технике массажа, врач перемещает застойную жидкость в бронхи и трахею, а затем при помощи спровоцированного кашля удаляет ее из организма.
При помощи техники дренажного массажа врач добивается следующих эффектов:
- стимулирует мышечные сокращения бронхов, вызывая тем самым продуктивный кашель, который и выводит мокроту;
- выводит патологическую жидкость из внутренних органов в совокупности с болезнетворными микроорганизмами и паразитами, если таковые имеются;
- сокращает интоксикационную нагрузку.

Положительные результаты наблюдаются уже после проведения первой процедуры, но для достижения максимального очищающего эффекта массаж проводят 3 раза в день в течение недели.
Дыхательная гимнастика
При обострении бронхита дыхательная гимнастика может стать хорошим подспорьем в лечении заболевания. Важно, чтобы пациент четко соблюдал принципы дыхания: схему чередования серий вдохов и вдохов и правила их проведения:
- вдохи и выдохи следует делать попеременно: сначала вдыхать носом и выдыхать ртом, затем – наоборот;
- вдох должен быть коротким, энергичным и резким;
- выдох – произвольным.

Схема выполнения упражнения такая:16 носовых вдохов, 3-5 секунд пауза, 16 ротовых вдохов. Комплекс включает 3 подхода. Гимнастику рекомендуется выполнять 2 раза в день на протяжении 2-3 недель.
Мокрота при бронхите у детей
Облегчить кашель и вывести мокроту у детей можно натуральными средствами: травяными отварами, настойками, полосканиями. Хорошо помогают:
- отвар перечной мяты;
- сироп из корня солодки;
- настой душицы или термопсиса;
- полоскание горла и ингаляции отваром ромашки;
- теплое молоко с добавлением соды и прополиса на ночь.
[btpr_shortcode_videogallery links=”vDiDGKKRQ-s”]
При хроническом бронхите ребенку на ночь можно давать теплое молоко с козьим жиром и медом (200 мл молока, 20 г меда и 20 г жира). Важно, чтобы у больного не было аллергии на молочные продукты и мед.
Эффективно разжижает и выводит мокроту настой сосновых почек, добавленный в теплое молоко.
Отзывы
Наталья, 32 года, Москва: «Хронический бронхит заработала еще в детстве. С тех пор мучаюсь 3-4 раза в год. Первые дни обострения самые ужасные: бронхит без мокроты разрывает грудь и днем, и ночью. Спасает только молоко с медом и отвар ромашки».
Ольга, 40 лет, Калуга: «Всем рекомендую с первых дней бронхита заниматься дыхательной гимнастикой. Облегчение дыхания и смягчение кашля наступает буквально со 2 дня. Если гимнастику выполнять перед сном, то ночь проходит практически без приступов».